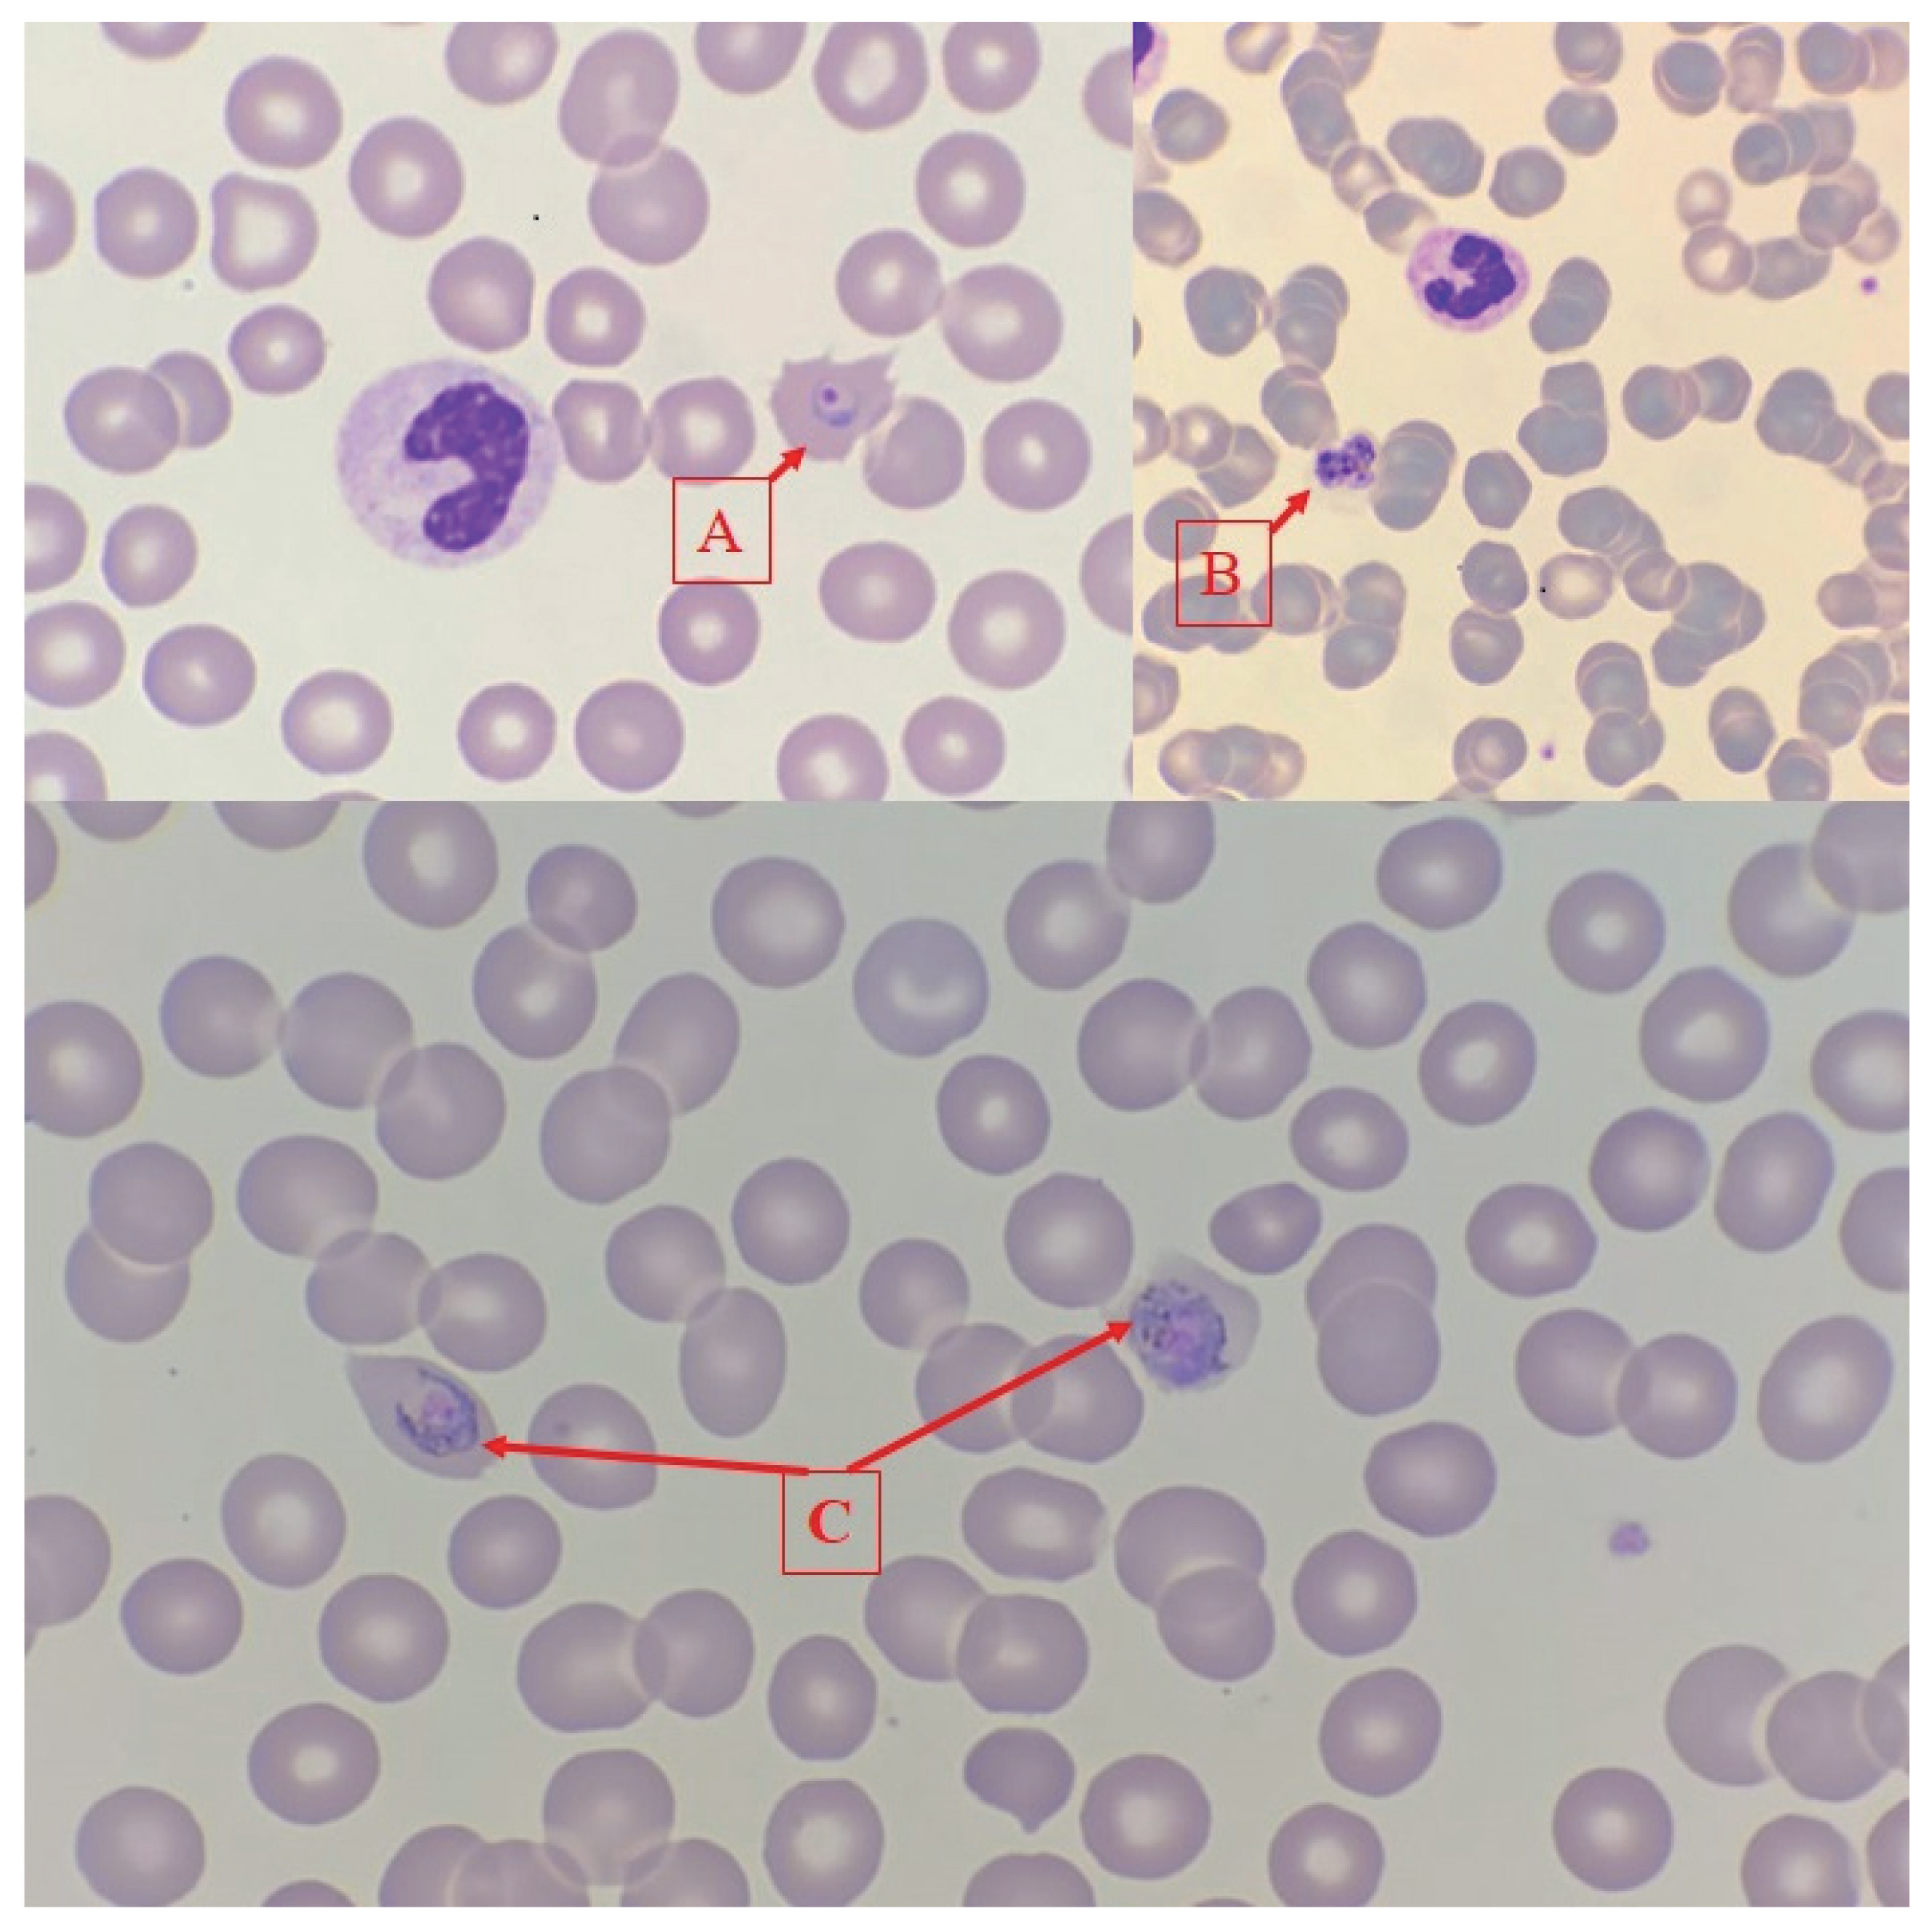
0

Abstract
The COVID-19 pandemic continues to be a major health problem worldwide. Timely diagnosis of co-infections mimicking COVID-19, such as malaria, might be challenging particularly in non-endemic areas. We report the first case of COVID-19 and Plasmodium ovale malaria co-infection from our region aiming to highligt the importance of travel history and prophylaxis in malaria management in the context of pandemic. The galloping sound can sometimes be a harbinger of zebra besides the horse.
-
Key words: Plasmodium ovale, COVID-19, malaria, artesunate, SARS-CoV-2
INTRODUCTION
The COVID-19 pandemic, which has left 19 months behind, continues to affect all aspects of life worldwide. Turkey ranks 9th in terms of the total number of cases in the world [
1]. As the attention is focused entirely on the pandemic disease, difficulties may be experienced in the timely diagnosis of co-infections. While the diagnosis of malaria is already elusive in a non-endemic country, this difficulty appears to be further increased due to the similarity of symptoms and findings with COVID-19 [
2]. For the last 10 years, only imported cases of malaria have been reported from Turkey. Imported plasmodium ovale is rarely reported as alone or an agent of mixed infection in travelers returning from Africa and accounts for 2.4% of the whole cases, while the rest are due to
P. falciparum and
P. vivax [
3,
4].
Malaria and COVID-19 have similar clinical aspects and both may negatively affect the course of each other [
5–
8]. While a severe course of malaria is not expected from
Plasmodium ovale, findings of organ failure may occur due to the temporarily impaired immunity by COVID-19 and the relatively increased parasite burden due to the delay in diagnosis.
We present here a case of COVID-19 and imported P. ovale malaria co-infection and aim to demonstrate how these 2 infections interact with each other, both diagnostically and clinically.
CASE DESCRIPTION
A 38-year-old male patient without any co-morbid disease admitted with fatigue and fever for 7 days. He was diagnosed as COVID-19 with a positive SARS-CoV-2 PCR test and was given favipiravir as antiviral and enoxaparine as anticoagulant, according to national guidelines [
9], 5 days prior to his admission to our center. His symptoms were not resolved despite antiviral treatment. He described a 5 days business journey to Ghana, a West African country, 8 days prior to his symptoms. He did not receive anti-malarial prophylaxis. On physical examination; his body temperature was 37.9°C, blood pressure 110/70 mmHg, respiratory rate 20/min and oxygen saturation was 98% in ambient air. No other pathological finding was detected. Laboratory tests revealed; CRP: 53 mg/L (0–5 mg/L) procalcitonin: 0.083 ng/ml (0–0.5 ng/ml) AST: 21 IU/L, ALT: 28 IU/L, LDH: 309 IU/L, Ferritin: 1,219 ng/ml, D-dimer: 1.2 mg/L WBC: 5,100/μl, HGB: 13.2 g/dl, PLT: 125,000/μl. Giemsa stained blood smear for malaria and rapid antigen test for
P. falciparum and
P. vivax were negative. His chest computerized tomography (CT) revealed ground glass opacities in bilateral lungs, compatible with Covid-19. Control nasopharyngeal swab PCR was positive for SARS-CoV-2.
He was evaluated as hyperinflammatory syndrome secondary to COVID-19, favipiravir treatment was extended for another 5 days, vitamin D 20,000 U/day and colchicine 0.5 mg q8h po were initiated for immunomodulation and daily dose of enoxaparin-sodium was increased to 4,000 U sc q12 hr.
As his fever continued (>38°C) on the third day of follow-up he was hospitalized for further evaluation and treatment. His physical examination was normal and he was hemodynamically stable while laboratory tests revealed deterioration as follows; CRP: 241 mg/L procalcitonin: 18 ng/ml, AST: 148 IU/L, ALT: 224 IU/L, LDH: 1,019 IU/L, direct bilirubin: 0.37 mg/dl, Ferritin: >2,000 ng/ml, D-dimer: 3.3 mg/L, WBC: 7,500/μl, HGB: 10.2 g/dl, PLT: 98,000/μl. SARS-CoV-2 PCR was detected negative. Peripheral blood smear was obtained due to continued fever and intra-erythrocyte trophozoites with typical stony ring appearance and schizonts in maturation stage were detected (
Fig. 1).
He was diagnosed as complicated malaria, his blood sample was sent to National Reference Parasitology Laboratory for species level identification with molecular methods and was given intravenous artesunate 2.4 mg/kg at 0, 12, 24, 48, 72, 96, and 120 hr, as recommended in the guidelines [
10]. Colchicine was discontinued. The patient’s symptoms were resolved within the 24 hr of treatment, blood platelet count returned to normal, control blood smears became negative. Liver function tests and acute phase reactants tended to regress. After 5 days of iv artesunate treatment, he was switched to oral artemeter lumefantrine which was given for 3 days. Daily blood smears remained negative and laboratory tests on day 8 were normal as follows; CRP: 1.58 mg/L AST: 15 IU/L, ALT: 49 IU/L, LDH: 267 IU/L, direct bilirubin: 0.17 mg/dL, D-dimer: 0.51 mg/L, WBC: 5,600/μl, HGB: 12 g/dl, PLT: 461,000/μl. The Real Time PCR test result revealed
Plasmodium ovale. After confirming that the blood G6PD level was normal, he was discharged with a prescription of 2-week primaquine for hypnozoite-acting treatment to prevent relapses.
DISCUSSION
This report covers the first case of COVID-19 and Plasmodium ovale malaria co-infection detected in our region. By presenting this case, we aimed to draw attention to a rare travel-related infection masked by a pandemic infection. Misinterpretation of patients with similar clinical and laboratory findings as COVID-19 infection is common, in the pandemic setting. Malaria symptoms and signs are similar to COVID-19. Both diseases can also fever, myalgia, fatigue, headaches, gastrointestinal symptoms and cytokine storm. It becomes more challenging when COVID-19 is confirmed with positive PCR test and typical radiological findings, while the screening tests for the concomitant infection are negative, as in our case. It is of vital importance to complete the differential diagnostic work-up particularly in case of deterioration despite treatment.
COVID-19 can lead to cytokine storm, which is responsible for the more severe manifestations of the disease.Cytokine response associated with systemic illness has been postulated to induce vivax malaria relapses. [
11]. The clinical deterioration of the patient with ongoing fever, increasing CRP, ferritin, LDH, transaminase levels and decreasing PLT counts in the second week were attributed to cytokine storm due to COVID-19 and favipiravir related liver toxicity at first. However increasing procalcitonin and decreasing hemoglobin levels in the course led us consider severe falciparum malaria which was initially screened as negative. Procalcitonin has been reported among indicators of severe falciparum malaria [
12].
At that point, intravenous treatment with arthesunate was initiated before confirmation of the malaria in species level. The response to the treatment was dramatic in the first day owing to the low level of parasitemia, specific to non-falciparum malaria. The case was not categorically “severe malaria” but was complicated with a systemic viral co-infection.
Travel history remains important in the differential diagnosis even in pandemic conditions. Malaria must be considered first in patients returning from endemic regions. Ghana is a malaria-endemic West African country,
P. falciparum being the most prevalent species with a prevalence of 98% while
P. ovale accounts for the 1% of the cases [
13].
Our case once again demonstrates the importance of malaria prophylaxis. If the patient had received prophylaxis for malaria during his travel to Ghana, he could have both protected from malaria and could have a less severe course of COVID-19. Hence there are studies showing that atovaquone/proguanil, which is routinely recommended and provided for malaria prophylaxis in Turkey, is somehow effective against SARS-CoV-2 virus [
14,
15].
Pandemic SARS-CoV-2 infection may mask malaria in returning travelers. Diagnosing non-falciparum and non-vivax malaria is relatively more elusive due to low parasitemia in blood smear and negativity in routine rapid antigen tests. Molecular testing is recommended for confirmation. The galloping sound can sometimes be a harbinger of zebra besides the horse.
Notes
-
The authors declare that they have no conflicts of interest.
Fig. 1(A) Intra-erythrocytic trophozoite, (B) Mature schizont, (C) Intra-erythrocytic immature schizont indicating Plasmodium ovale.

References
- 1. Worldometer. Report Coronavirus Cases [Internet]; [cited 2021 Feb 7]. Available from: https://www.worldometers.info/coronavirus/#countries
- 2. World Health Organization. Vector-borne and parasitic diseases-Malaria-Turkey [Internet]; [cited 2021 Feb 7]. Available from: https://www.euro.who.int/en/health-topics/communicable-diseases/vector-borne-and-parasitic-diseases/malaria/country-work/turkey#:~:text=Malaria%20risk%20exists%20only%20inareas%20where%20tourism%20is%20concentrated
- 3. Beşli Y, Bengür FB, Akyar I, Kurt Ö. The ınvestigation of malaria cases in a central laboratory in İstanbul region for a period of fifteen years. Turkiye Parazitol Derg 2019;43:65-69. https://doi.org/10.4274/tpd.galenos.2018.5939
- 4. Delıbaş SB, Akisü C, Aksoy U, Ozkoç S, Sari B, Tekış D, Bıberoğlu K. Plasmodium falciparum ve Plasmodium ovale’nin Etken Olduğu İmporte Bir Miks Sıtma Olgusu. Turkiye Parazitol Derg 2005;29:63-67. (in Turkiye).
- 5. Di Gennaro F, Marotta C, Locantore P, Pizzol D, Putoto G. Malaria and COVID-19: common and different findings. Trop Med Infect Dis 2020;5:141. https://doi.org/10.3390/tropicalmed5030141
- 6. Correia MJ, Frade L, Guerreiro R, Araujo I, Baptista T, Fonseca C, Mansinho K. A patient with severe malaria and COVID-19: how do you tell the difference between these ınfections? Eur J Case Rep Intern Med 2020;7:002007. https://doi.org/10.12890/2020_002007
- 7. Sardar S, Sharma R, Alyamani TYM, Aboukamar M. COVID-19 and Plasmodium vivax malaria co-infection. IDCases 2020;21:e00879. https://doi.org/10.1016/j.idcr.2020.e00879
- 8. Hussein MIH, Albashir AAD, Elawad OAMA, Homeida A. Malaria and COVID-19: unmasking their ties. Malar J 2020;19:457. https://doi.org/10.1186/s12936-020-03541-w
- 9. COVID-19 Bilgilendirme Platformu. Erişkin Hasta Tedavisi [Internet]; [cited 2021 Feb 7]. Available from: https://covid19.saglik.gov.tr/TR-66926/eriskin-hasta-tedavisi.html
- 10. World Health Organization. Guidelines for the Treatment of Malaria. 3rd ed. Geneva, Switzeland. World Health Organization; 2015. p. 1-313 https://apps.who.int/iris/handle/10665/162441
- 11. White NJ. Determinants of relapse periodicity in Plasmodium vivax malaria. Malar J 2011;10:297. https://doi.org/10.1186/1475-2875-10-297
- 12. Amoah LE, Donu D, Abuaku B, Ahorlu C, Arhinful D, Afari E, Malm K, Koram KA. Probing the composition of Plasmodium species contained in malaria infections in the Eastern region of Ghana. BMC Public Health 2019;19:1617. https://doi.org/10.1186/s12889-019-7989-1
- 13. Hollenstein U, Looareesuwan S, Aichelburg A, Thalhammer F, Stoiser B, Amradee S, Chullawichit S, El Menyawi I, Burgmann H. Serum procalcitonin levels in severe Plasmodium falciparum malaria. Am J Trop Med Hyg 1998;59:860-863. https://doi.org/10.4269/ajtmh.1998.59.860
- 14. Sağlığı Seyahat. Health status of countrıe [Internet]; [cited 2021 Feb 8]. Available from: https://www.seyahatsagligi.gov.tr
- 15. Yang CW, Peng TT, Hsu HY, Lee YZ, Wu SH, Lin WH, Ke YY, Hsu TA, Yeh TK, Huang WZ, Lin JH, Sytwu HK, Chen CT, Lee SJ. Repurposing old drugs as antiviral agents for coronaviruses. Biomed J 2020;43:368-374. https://doi.org/10.1016/j.bj.2020.05.003
Citations
Citations to this article as recorded by

- Optimal control analysis of a mathematical model of malaria and COVID-19 co-infection dynamics
Abou Bakari Diabaté, Boureima Sangaré, Ousmane Koutou
Journal of Biological Dynamics.2025;[Epub] CrossRef - Safety and Efficacy of Imatinib, Nilotinib, and Artesunate in COVID-19
Patients: A Systematic Review of Current Evidence
Ehsan Ghavimehr, Ali Zand, Seyed Ahmad SeyedAlinaghi, Amirali Karimi, Hamid Zaferani Arani, Pegah Mirzapour, Zahra Pashaei, Esmaeil Mehraeen, Omid Dadras
Anti-Infective Agents.2024;[Epub] CrossRef - COVID-19 and malaria co-infection: a systematic review of clinical outcomes in endemic areas
Amal H. Mohamed, Ebtihal Eltyeb, Badria Said, Raga Eltayeb, Abdullah Algaissi, Didier Hober, Abdulaziz H. Alhazmi
PeerJ.2024; 12: e17160. CrossRef - Effect of the second and third COVID-19 pandemic waves on routine outpatient malaria indicators and case management practices in Uganda: an interrupted time series analysis
Pius Mukisa, Freddy Eric Kitutu, Arthur Mpimbaza, Jaffer Okiring, Joan N. Kalyango, Joaniter I. Nankabirwa
Malaria Journal.2024;[Epub] CrossRef - Mixed infection with COVID-19 and tropical malaria (case report)
Dmitriy O. Efremov, Ainur R. Khuramshin, Sergey S. Кozlov, Nikolay I. Gulyaev
Epidemiology and Infectious Diseases.2023; 28(1): 53. CrossRef - Co-infection of COVID-19 and parasitic diseases: A systematic review
Fatemeh Nemati Zargaran, Mosayeb Rostamian, Sara Kooti, Hamid Madanchi, Keyghobad Ghadiri
Parasite Epidemiology and Control.2023; 21: e00299. CrossRef - Clinical characteristics of malaria in COVID-19: A systematic review of case reports
Chandana Rayella, Praveen Devanandan, Kavitha Rasuri, Sai Sudha Yerravelly, Sanjana Andem, Ranadheer Chowdary Puvvada
Tropical Parasitology.2023; 13(1): 22. CrossRef - MIS-C and co-infection with P. vivax and P. falciparum in a child: a clinical conundrum
Michela Scalisi, Salvatore Giordano, Laura Antonella Canduscio, Maria Concetta Failla, Luca Messina, Elisa Sferrazza, Raffaella Rubino, Lucia Siracusa, Veronica Vanella, Antonio Cascio, Claudia Colomba
Italian Journal of Pediatrics.2022;[Epub] CrossRef - Co-Infection with Plasmodium vivax and COVID-19 in Thailand
Parat Boonyarangka, Kittijarankon Phontham, Sabaithip Sriwichai, Kamonporn Poramathikul, Krit Harncharoenkul, Worachet Kuntawunginn, Napat Maneesrikhum, Sarayouth Srisawath, Chanida Seenuan, Chattakorn Thanyakait, Kanjana Inkabajan, Suda Pludpiem, Kingkan
Tropical Medicine and Infectious Disease.2022; 7(8): 145. CrossRef - SARS-CoV-2 and Plasmodium falciparum Co-Infection in a Returning Traveler
Qian Huang, Wen-Jie Xu, Xiao-Xiao Wang, Xuan Zhang, Ke-Nu Pan, Jia-Qi Zhang, Hua-Liang Chen, Wei Ruan, Li-Nong Yao
Frontiers in Public Health.2022;[Epub] CrossRef - The striking mimics between COVID-19 and malaria: A review
Emadeldin Hassan E. Konozy, Makarim El-fadil M. Osman, George Ghartey-Kwansah, Hind Mohamed Abushama
Frontiers in Immunology.2022;[Epub] CrossRef